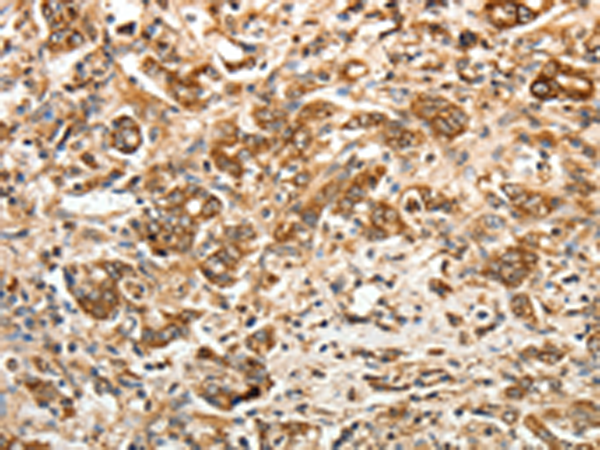

-
分类: 科研抗体货号: P07328别名: DRM; HMPS; MPSH; PIG2; CRAC1; CRCS4; DAND2; HMPS1; IHG-2; DUP15q; C15DUPq; GREMLIN; CKTSF1B1应用: WB反应种属: Human, Mouse, Rat
-
分类: 科研抗体货号: P07327别名: GLUR3; mGlu3; GPRC1C; MGLUR3应用: IHC反应种属: Human, Mouse, Rat
-
分类: 科研抗体货号: P07344别名: HD8; WTS; RPD3; CDA07; CDLS5; MRXS6; HDACL1应用: WB,IHC反应种属: Human, Mouse, Rat
-
分类: 科研抗体货号: P07326别名: HLP; CCPI; CGL1; CSPB; SECT; CGL-1; CSP-B; CTLA1; CTSGL1应用: IHC反应种属: Human
-
分类: 科研抗体货号: P07331别名: ECGP; GP96; TRA1; GRP94应用: WB,IHC反应种属: Human, Mouse, Rat
-
分类: 科研抗体货号: P07343别名: HD6; JM21; CPBHM应用: IHC反应种属: Human
-
分类: 科研抗体货号: P07324别名:应用: IHC反应种属: Human, Mouse, Rat
-
分类: 科研抗体货号: P07330别名: RO; CRT; SSA; cC1qR应用: WB,IHC反应种属: Human, Mouse, Rat
-
分类: 科研抗体货号: P07341别名: H1C; H1.2; H1F2; H1s-1; HIST1H1C应用: WB反应种属: Human
-
分类: 科研抗体货号: P07323别名: ASH; Grb3-3; MST084; NCKAP2; MSTP084; EGFRBP-GRB2应用: IHC反应种属: Human, Mouse, Rat

鄂公网安备42018502007531号
鄂公网安备42018502007531号

